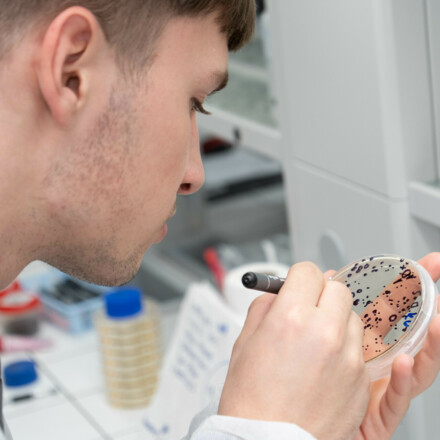

O nás
Zažij, co znamená měnit svět.
O nás: Nejstarší fakulta v nejnovějším obalu
- 80 % – studentů je u nás spokojených (zbytek jsou prváci, kteří to zatím neví)
- 1991 – rok, od kterého učíme, jak vracet krajinu zpátky do života
- CPTO – naše nové moderní sídlo za miliardu korun
- 40 minut – autem do Národního parku České Švýcarsko, se kterým spolupracujeme
- 1 hodina – a jsi tu vlakem z Prahy
#studujfzp, #vedavenku, #zazijcoznamenamenitsvet
Jsme nejstarší fakultou životního prostředí v Česku, ale sídlíme v tom nejnovějším moderním kampusu, jaký u nás najdeš. Vznikli jsme před 35 lety, abychom pomohli uzdravit zničený sever Čech. Povedlo se.
Teď řešíme zelenou energii, recyklaci a k ochraně přírody využíváme vyspělé technologie. Hledáš školu, kde se nesedí jen v lavicích? U nás se zapojíš do projektů, které skutečně mění svět.
Od dronů po zkumavky
Zapomeň na představu, že studium životního prostředí je o poznávání kytek (i když i to umíme). U nás je to high-tech disciplína. Budeš létat s drony, tvořit 3D modely krajiny nebo v laboratořích zkoumat nanomateriály. Řešíme, jak recyklovat lithiové baterie, jak využít odpad jako zdroj surovin nebo jak pomocí satelitních dat sledovat sucho.
Měnit svět doopravdy
Firmy dnes zoufale hledají odborníky, kteří umí vyřešit udržitelnost a pracovat s moderními daty. U nás získáš know-how, za které se platí. Spolupracujeme s giganty jako ČEZ, SPOLCHEMIE či ORLEN Unipetrol. Ti často přímo zadávají témata bakalářských i diplomových prací. Nebudeš tak psát nic „do šuplíku“, ale řešit úkoly, které jsou užitečné.
Co o nás řekli absolventi
„Dostaneš do ruky špičkové technologie. A čeká tě magický kontrast drsného, historií opředeného kraje s nádhernou přírodou.“ – Oto Weber
„Mile mě překvapilo, jak moc fakulta kope za studenty. Neustále vylepšuje zázemí a otevírá nám dveře k novým příležitostem.“ – Zuzana Pfeiferová
„Jděte do toho! Fakulta má skvělé odborníky, kteří vás vezmou na neuvěřitelná místa.“ – Monika Dubská
„Jestli máš chuť nezůstat jen u slov, ale věci skutečně měnit, FŽP v Ústí je pro tebe nejlepší základna.“ – Marcela Synková
Nejsi jen číslo v systému
U nás tě učitelé budou znát jménem. Jsme tým, kde akademiky zajímá tvůj názor i tvoje budoucnost. Pokud chceš, můžeš vyjet na Erasmus do Norska, Finska, Portugalska a dalších zemí. Jestli hledáš školu, která má smysl, atmosféru a budoucnost, jsi tu správně.
Kde nás najdeš
Fakulta životního prostředí
Univerzita Jana Evangelisty Purkyně v Ústí nad Labem
Pasteurova 3632/15
400 96 Ústí nad Labem
Přihlášky a přijímačky
Přihlášky a přijímačky
Den otevřených dveří je 12. 2. 2026
Jak se k nám dostat?
Hledáme parťáky, kteří mají o obor skutečný zájem. Čeká tě motivační pohovor, kde si tě trochu proklepneme. Nejde o stresování u tabule, ale musíme vidět, že víš, do čeho jdeš a že to myslíš vážně. Pokud jsi bodoval v nějaké středoškolské soutěži, určitě přines diplom s sebou – to se u nás hodně počítá.
Po motivačním pohovoru tě kampusem provedou naši studenti. Učitelé u toho za zády stát nebudou, takže se můžeš zeptat na cokoliv – a ne, nemusí to být jen dotaz, kde jsou záchody. Dostaneš upřímné odpovědi, jak to u nás chodí.
- Elektronická přihláška: 800 Kč
Aktuality
Kontakt
Fakulta životního prostředí
Univerzita Jana Evangelisty Purkyně v Ústí nad Labem
Pasteurova 3632/15
400 96 Ústí nad Labem